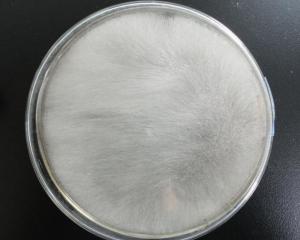
毛霉菌

毛霉菌图片 结构

毛霉的介绍
图片尺寸268x378
实验二,霉菌的形态观察ppt
图片尺寸1080x810
霉菌的形态和结构图文并茂
图片尺寸445x326
霉菌的形态和结构图文并茂
图片尺寸617x411
霉菌的形态和结构图文并茂
图片尺寸291x321
霉菌的形态和结构图文并茂
图片尺寸435x238
众里寻它千百度,蓦然回首,绒绒毛霉在深处
图片尺寸1000x515
毛霉菌的结构.白色背景上分离孢子囊的菌丝体图片
图片尺寸546x612
毛霉菌
图片尺寸300x240
动物细胞结构图,画圈部分是什么?
图片尺寸606x810
22.霉菌的形态结构和菌落特征.
图片尺寸1080x810
呵护母婴健康的秘密 尽然是因为它?
图片尺寸600x519
发酵香肠ppt
图片尺寸1080x810
真菌感染的同时侵犯鼻窦粘膜,骨壁,并向鼻窦外侧周围结构和组织侵犯
图片尺寸512x512
猜你喜欢:霉菌的结构图片毛霉菌图片毛霉菌结构毛霉菌病图片毛霉菌患者图片毛霉菌感染图片毛霉菌印度图片霉菌的结构示意图霉菌结构图及名称霉菌的形态结构图毛霉菌皮肤感染图片毛霉菌感染症状图片霉菌图片印度毛霉菌感染图片霉菌结构女性霉菌图片霉菌长什么样子图片毛霉菌毛霉菌人霉菌的形态结构毛霉菌形态毛霉菌病霉菌和滴虫的区别图片霉菌用手抠出来的图片毛霉菌感染霉菌的细胞结构人感染毛霉菌女性霉菌感染早期图片毛霉菌病毒毛霉菌显微镜摄图网图片创意社区14天隔离证明模板的黎波里黎巴嫩读者封面图片咒轮纸一次烧几张象足漆树生桩周星驰功夫颁奖典礼龚俊戴眼镜的照片纯白紫罗兰眼信鸽红色眼睛的鸟的图片赛乃姆舞蹈图片excel画仓库平面图